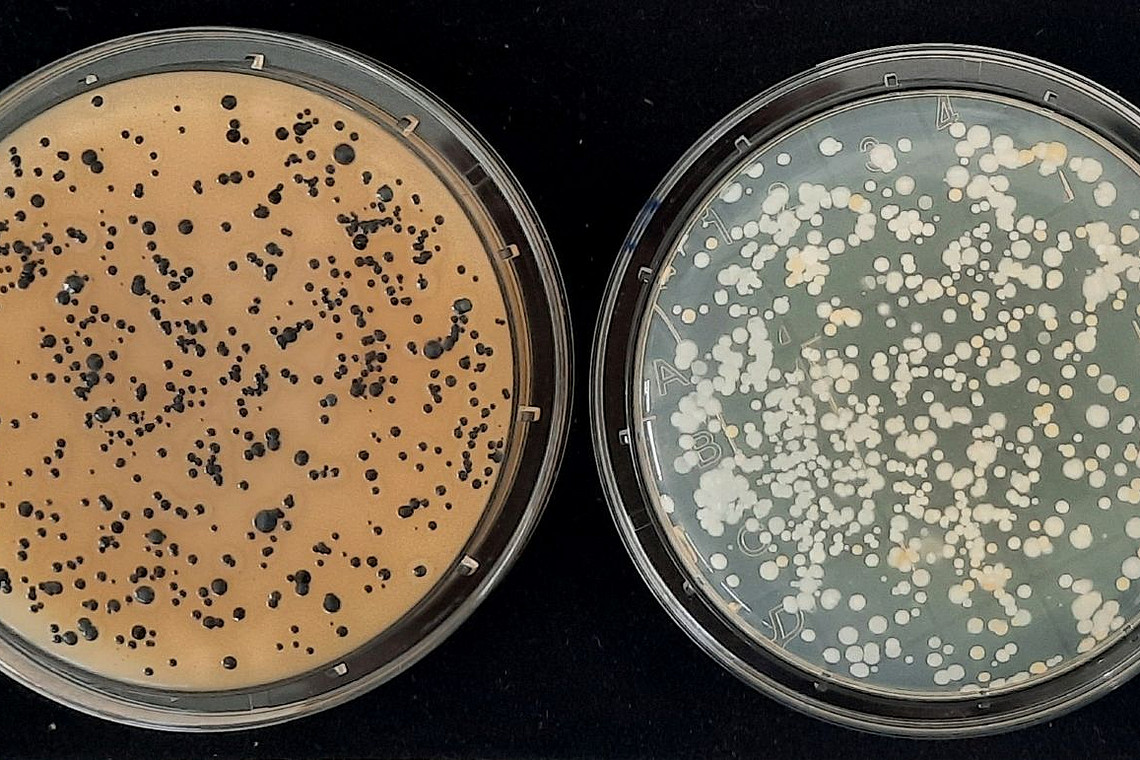
Mit den Abklatschplatten lassen sich Aussagen treffen, wie viele Organismenkolonien auf einer bestimmten Fl&auml;che vorhanden sind.

Willkommen im Labor für Lebensmittelmikrobiologie
Das Labor für Lebensmittelmikrobiologie steht für praxisnahe Forschung, moderne Analytik und starke Lehre in den Bereichen Lebensmittelmikrobiologie, Lebensmittelsicherheit, Hygiene und Qualität. Im Labor werden mikrobiologische Fragestellungen entlang der Lebensmittelkette untersucht, hygienische Risiken bewertet und praxisrelevante Lösungen für aktuelle Herausforderungen in Wissenschaft und Lebensmittelpraxis entwickelt. Neben der Analytik von Bakterien, Hefen und Schimmelpilzen können zudem intrinsische Parameter von Lebensmitteln, die das Wachstum von Mikroorganismen beeinflussen, wie der aW-Wert und der pH-Wert gemessen werden sowie Umgebungsanalysen (Luftkeimsammlungen und Abklatschproben) durchgeführt werden. Ebenfalls ist das Färben von Bakterien möglich (Gramfärbung) sowie die damit zusammenhängende Klassifizierung der Bakterien (grampositiv/gramnegativ) und die Ermittlung der Bakterienmorphologie mittels Mikroskops.
Gleichzeitig ist das Labor ein zentraler Lern- und Forschungsort für Studierende: Im Zusammenhang mit dem Laborpraktikum des Bachelorstudiengangs Ökotrophologie können Studierende freiwählbare Lebensmittel auf bestimmte Mikroorganismen analysieren, um eine Einschätzung über den mikrobiellen Status des Lebensmittels zu erlangen und anhand der Ergebnisse Handlungsempfehlungen ableiten zu können.
Regelmäßig werden ebenfalls im Rahmen laborexperimenteller Bachelor- und Masterarbeiten aktuelle Themen der Lebensmittelmikrobiologie wissenschaftlich bearbeitet und praxisnahe Fragestellungen beantwortet. So verbindet das Labor Forschung, Lehre und Anwendung auf besonders anschauliche Weise.
Standort am Campus Bergedorf
Das Labor für Lebensmittelmikrobiologie befindet sich im Südflügel im 2. Stock am Ende des Ganges in Raum S2.01.
(Aufzug A1S)